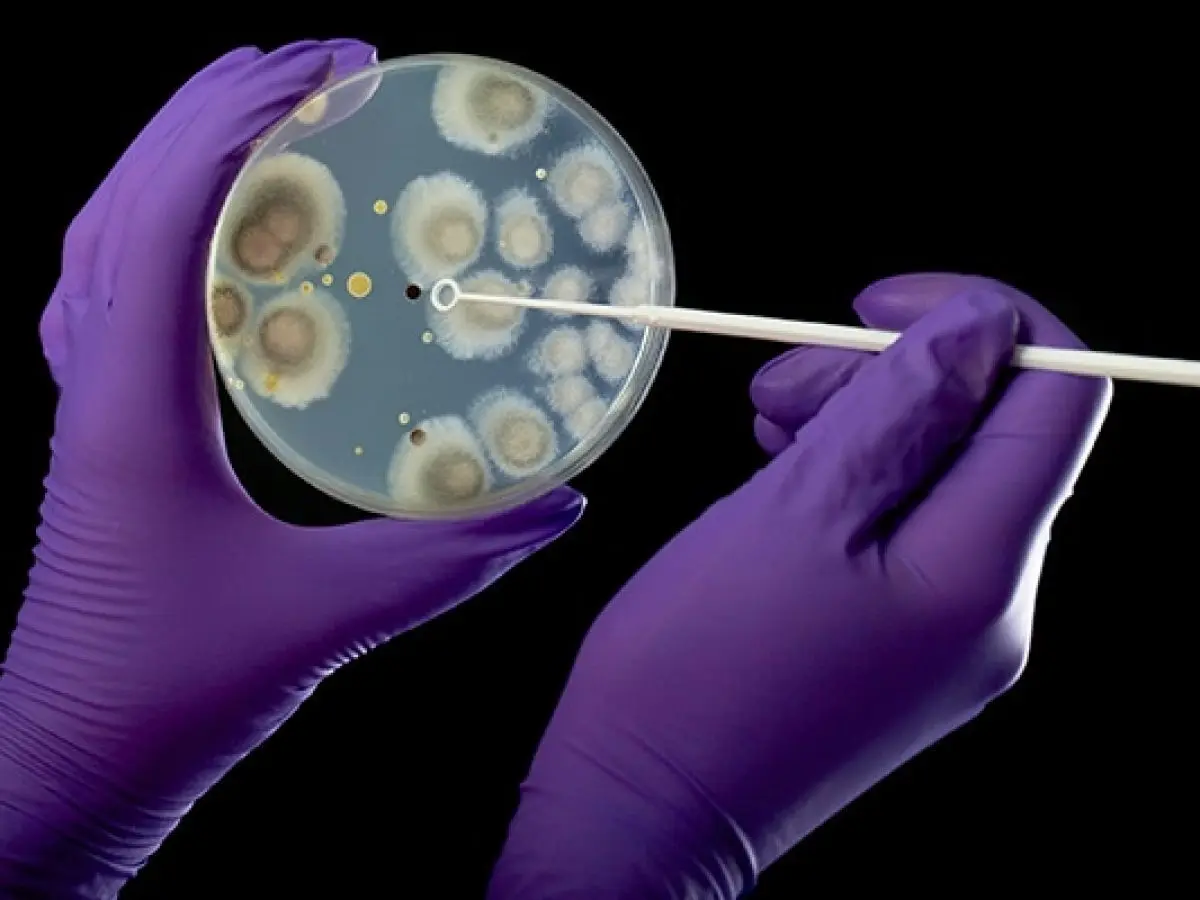

Video que muestra parásito intraocular no tiene relación con vacunas de covid
Una búsqueda inversa con un fotograma del video demuestra que la grabación es antigua. Primero, el rastreo consigue la misma secuencia en BitChute, una plataforma británica que se utiliza para albergar videos.
Actualizado: 23 de Julio, 2025, 07:20 AM
Publicado: 01 de Septiembre, 2023, 01:45 PM
Bogotá.– Bogotá.- Un video que muestra a un gusano moviéndose dentro de un ojo humano no tiene nada que ver con una reacción adversa a la vacunación contra la covid-19, sino que se trata de un parásito común en África que es transmitido por la picadura de un insecto.
EFE Verifica recibió una consulta a través de su canal de WhatsApp (+52 1 55 6166 2482) sobre una publicación en X, antes Twitter, que difunde una grabación en la que se observa a un gusano vivo dentro del globo ocular de una persona.
"Un médico grabó este video luego de comprobar que era posible ver una criatura con tentáculos a través de los ojos de un niño de 11 años, quien murió tras ser vacunado", sostiene el mensaje que acompaña la secuencia.
El mismo material también se comparte en Telegram, en un canal que acumula más de cien mil suscriptores y que habitualmente esparce desinformación sobre la pandemia.
HECHOS: La publicación más antigua encontrada de este video proviene de una cuenta de TikTok que nunca vincula las imágenes con las vacunas de la covid-19 y un médico inmunólogo consultado por EFE Verifica explica que las células vivas de un parásito no podrían introducirse al cuerpo humano por medio de una inyección. Las imágenes se corresponden con una infección parasitaria de la que se tiene amplio registro científico.
UN VIDEO DE TIKTOK QUE NO SE RELACIONA CON LAS VACUNAS
Una búsqueda inversa con un fotograma del video demuestra que la grabación es antigua. Primero, el rastreo consigue la misma secuencia en BitChute, una plataforma británica que se utiliza para albergar videos.
Sin embargo, un nombre de usuario visible en un costado de dicha publicación prueba que la secuencia se extrajo de TikTok, específicamente de una cuenta identificada con el alias "@Mefbrown".
La grabación se colgó en esa red social en octubre de 2021. El perfil es de un hombre que se describe como "doctor" y publica contenido médico sensible. No hay rastro del video en una fecha anterior a esta publicación.
El video en esa cuenta lleva un rótulo en francés que menciona: “No lo creerás, un fenómeno increíble”, mientras que en la descripción señala: “Vemos todo en este trabajo”.
En ninguna parte de la entrada se hace referencia a las vacunas contra la covid-19.
Además, EFE Verifica se comunicó con el número de teléfono vinculado a ese perfil, que tiene un prefijo de Camerún, y el interlocutor sostuvo ser el autor y rechazó que tuviese algo que ver con las inoculaciones.
Según la persona contactada, el diagnóstico fue la presencia de "parásito intraocular", llamado Loa loa.
NO ES POSIBLE QUE LO PROVOQUE UNA VACUNA
Lo anterior coincide con lo que declaró a EFE Verifica el inmunólogo colombiano John Mario González, coordinador del Laboratorio de Ciencias Básicas Médicas de la Universidad de Los Andes.
Al analizar el video, el especialista apuntó que lo se muestra en la cámara ocular de la persona es un tipo de parásitos, a los que se le conoce como filarias.
Precisamente, el Loa loa, tal y como se define en la página web de los Centros para el Control y Prevención de Enfermedades de Estados Unidos (CDC), es un "nematodo filárido" comúnmente llamado "gusano ocular africano".
El médico explica que para que este tipo de parásitos se introduzcan en el cuerpo humano necesitan de un insecto.
"Se llaman enfermedades transmitidas por un vector. Un insecto lo carga, se transforma, se inyecta y puede terminar en el ojo. Eso no tiene nada que ver con ninguna vacuna", aclara.
Asimismo, agrega que un organismo vivo de ese tipo nunca podría sobrevivir a las condiciones de congelación que requieren algunas inyecciones.
UN PARÁSITO COMÚN EN ÁFRICA, MUY DOCUMENTADO
El Loa loa es transmitido por dos especies de moscas del género Chrysops, de acuerdo a los CDC.
A través de una picadura, el insecto introduce la larva en el tejido cutáneo del ser humano y después el parásito migra a otros órganos.
La Academia Estadounidense de Oftalmología expone en su portal web que el Loa loa es endémico en países de África subsahariana, entre ellos, Camerún.
Las fotos de referencia que utiliza dicha Academia coinciden con lo que se ve en el video viral.
De igual forma, la Revista Estadounidense de Enfermedades Tropicales e Higiene también ilustran la infección por Loa loa con imágenes similares a las que se comparten en la grabación.
En conclusión, es falso que un video que muestra a un gusano moviéndose dentro de un ojo humano tenga relación con las vacunas del covid-19. Es un afección parasitaria transmitida por una mosca.

Agencia EFE
La Agencia EFE, o simplemente EFE, es una agencia de noticias internacional con sede en Madrid. Fue fundada en 1939 gracias al impulso del entonces ministro del Interior, Ramón Serrano Suñer, en la que participaron activamente: José Antonio Jiménez Arnau, Manuel Aznar Zubigaray y Vicente Gállego.
Biografía completa »